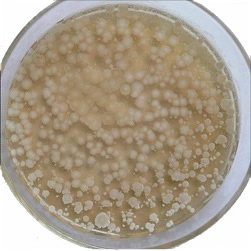

Superoxide Dismutase Cas No.: 9054-89-1
Product Name: Superoxide Dismutase
Cas No.: 9054-89-1
EINECS: 232-943-0
Appearance: White or light blue crystalline powder
Enzyme activity: 1000U/mg-10000U/mg
PH: 6.5~7.6
Activity
Superoxide dismutase (SOD) has powerful antinflammatory activity. For example, SOD is a highly effective experimental treatment of chronic inflammation in colitis. Treatment with SOD decreases reactive oxygen species generation and oxidative stress and, thus, inhibits endothelial activation and indicate that modulation of factors that govern adhesion molecule expression and leukocyte-endothelial interactions. Therefore, such antioxidants may be important new therapies for the treatment of inflammatory bowel disease.
Cosmetic uses
Superoxide dismutase (SOD) may reduce free radical damage to skin-for example, to reduce fibrosis following radiation for breast cancer. Studies of this kind must be regarded as tentative, however, as there were not adequate controls in the study including a lack of randomization, double-blinding, or placebo. Superoxide dismutase is known to reverse fibrosis, perhaps through reversion of myofibroblasts back to fibroblasts.